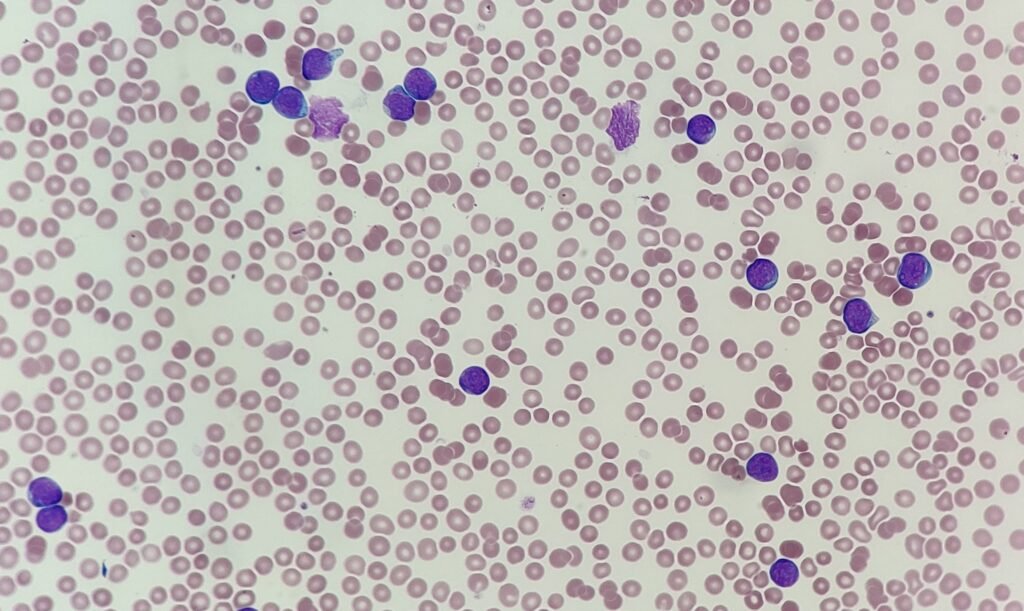
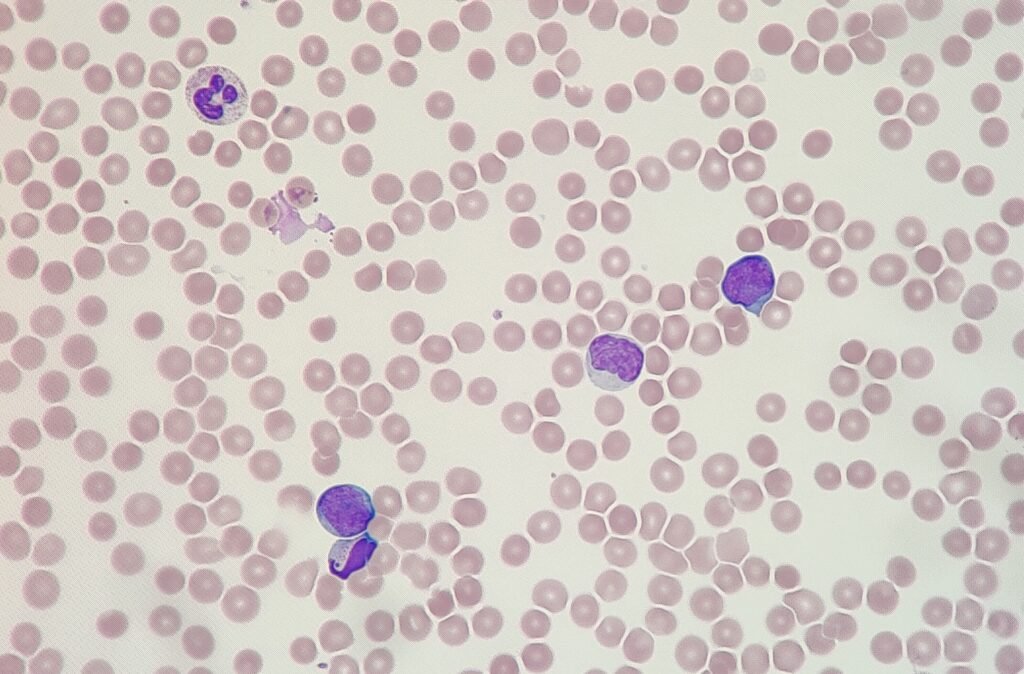
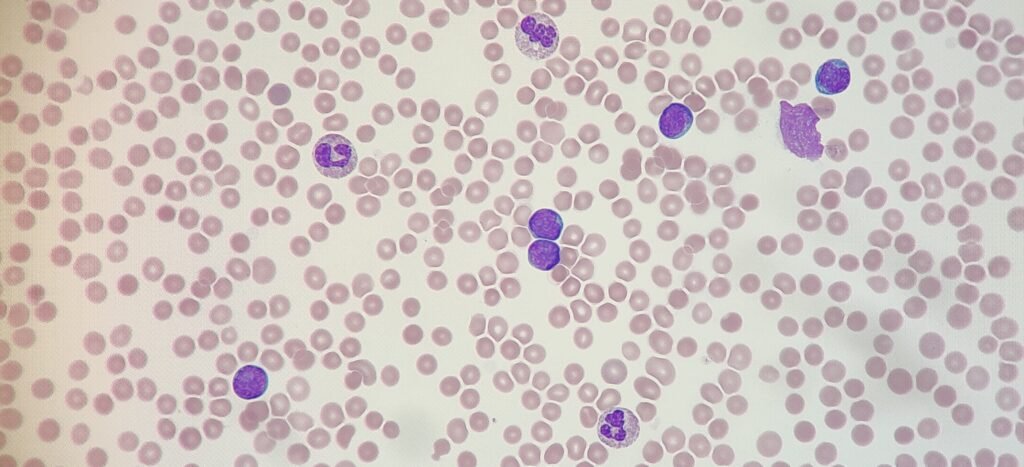
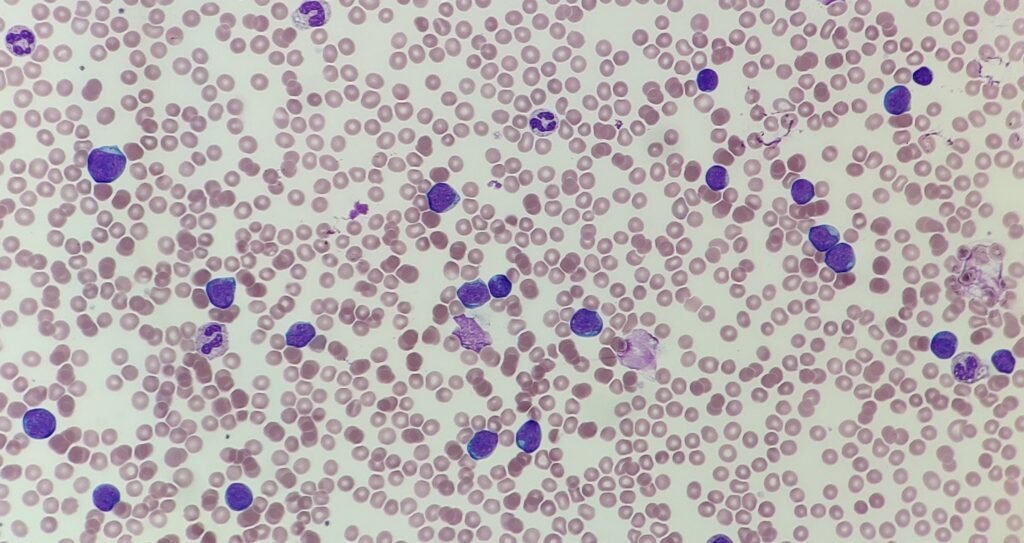

Morphology Monday | Case MM260413
This week’s case is a particularly poignant one. While working on Christmas day many years ago, I came across the results of a patient who had just celebrated their 18th birthday, only to then find themselves admitted to the hospital. What started as “holiday fatigue” quickly evolved into a clinical picture that demanded urgent haematological investigation.
The patient presented to the Emergency Department with a two week history of progressive lethargy and “bone pain” that made it difficult to enjoy the festivities. Their family also noted that the patient appeared unusually pale and had developed several unexplained bruises on their shins and arms despite no recent trauma.
Full blood count results:
- WBC: 81.25 x 109/L
- Hb: 114 g/L
- PLT: 61 x 109/L
Given these results, a blood film was made and a few images are below:

Given the age of the patient, clinical presentation and blood film images, what are your thoughts? Feel free leave your thoughts in the comments below or join the conversation on LinkedIn.
Privacy Policy | Refund & Return Policy | Only Cells LTD © 2025
